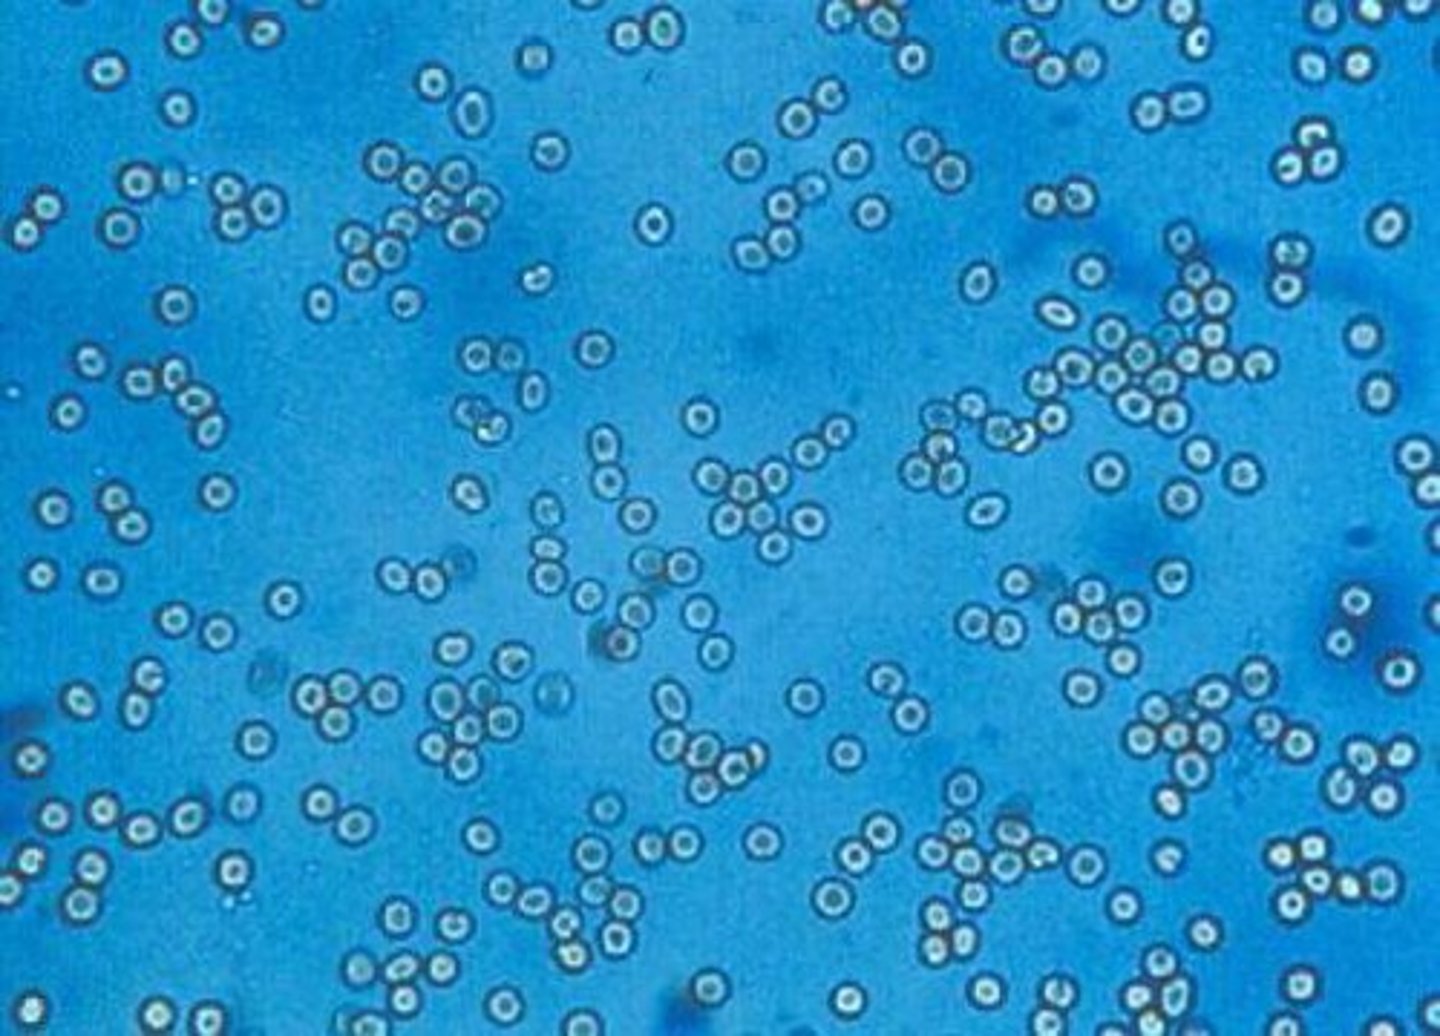
knowt flashcard image

TUTOR - Week 12
1/135
There's no tags or description
Looks like no tags are added yet.
Name | Mastery | Learn | Test | Matching | Spaced | Call with Kai |
|---|
No analytics yet
Send a link to your students to track their progress
136 Terms
What is a urinalysis?
Series of diagnostic tests used to evaluate the urinary tract and kidneys
What does a complete urinanalysis include?
gross examination, urine specific gravity, dipstick analysis, microscopic evaluation of urine sediment
cyctocentesis
collecting urine sample directly from the bladder with a syringe and needle (usually used for culture)
What are different ways you can collect urine from a patient?
cystocentesis, catherization, voided/free catch, manual expression, off the floor
What are contraindications for cycstocentesis on patients?
uncooperative patient, evaluating hematuria (lood contamination happens commonly in these samples), concerns for bladder cancer (can seed or spread it)
What are contraindications for urinary catheterization?
uncooperative patient, not a sterile sample, can cause mucosal damage and secondary infection
What are contraindications with obtaining a free catch urine sample?
not a sterile sample, higher risk of contamination by patient environment
What are contraindications of manual bladder expression?
not a sterile sample, higher risk of contamination, trauma risk to patient (NEVER manually express in a suspect or blocked patient)
What are you looking at with the gross evaluation of a urine sample?
color, turbidity(clarity), specific gravity, odor
What can red to red/brown urine indicate?
presence of hemoglobin and or myoglobin
Hemoglobinuria
hemoglobin in the urine due to IV hemolysis causing hemoglobin to spill into urine
Myoglobinuria
myoglobin in the urine due to muscle breakdown, muscle injury, strenuous exercise
What can dark yellow, orange, or brown urine indicate?
presence of bilirubin
Bilirubinuria
bilirubin in the urine due to cholestatic or hepatobiliary disease (bile unable to move from liver to small intestine)
How do you determine if it's hemoglobinuria or hematuria?
centrifuge the sample, RBCs will create a red pellet at the bottom (hemolysis), Hemoglobin will remain pink/red throughout the sample
What species normally have more turbid (cloudy) urine?
equine and rabbits due to normal mucus and crystals
What causes cloudiness in urine?
cells (inflammation), protein, mucus, crystals, lipids
How do you evaluate turbidity?
white paper test (hold sample up to a paper with writing on it and see if you can see through it)
What are words you can use to describe turbidity?
clear, cloudy, hazy, opaque, etc.
How is urine specific gravity measured?
refractometer held up to light
What does urine specific gravity evaluate?
nephron (kidney) functionality, how well loops of Henle and distal tubules are diluting urine
What are the kidneys responsible for?
eliminate waste (urea + creatinine), fluid, electrolyte, and acid-base balance, nutrient conservation, erythropoietin production
What should you use to clean a refractometer?
distilled water and kim wipe only!
What is the normal USG for a canine?
1.030-1.040
What is the normal USG for a feline?
1.035-1.045
Hyposthenuria
decreased USG, kidneys are diluting the urine, USG: < 1.005
Isosthenuria
Fixed USG 1.008-1.012, kidneys are unable to concentrate or dilute, happens in renal failure (75% or greater nephron functionality loss)
Hypersthenuria
increased USG, dehydration
Polyuria/Polydipsia
increased urine volume, increased drinking
Anuria
no urine production, occurs secondary to disease, EMERGENCY!!
Oliguria
decreased urine production, hyperthermia
What artifacts can cause falsely elevated USG?
hyperglycemia, hyperproteinemia, contrast medium, wrong refractometer used
What artifacts can cause falsely decreased USG?
non-temperature regulation
What does chemical evaluation of urine include?
dipstick or reagent strips include: glucose, bilirubin, ketones, blood, pH, protein
What values are not reported from the urine dipstick?
leukocytes, specific gravity (always do with refractometer), ascorbic acid, nitrite, urobilinogen
How does glucose end up in urine?
normally reabsorbed in the proximal tubules of kidneys, kidneys have a threshold for glucose reabsorption and once it is met glucose gets excreted in urine
What is a dogs renal threshold for glucose?
180-220mg/dL
What is a cats renal threshold for glucose?
200-280mg/dL
What is a horse/calves renal threshold for glucose?
150mg/dL
When do you most commonly see glucosuria?
excited or stressed animals, diabetes mellitus and hyperadrenocorticism (Cushing's)
Bilirubin on dipstick
small amounts normal in canines, detects conjugated bilirubin only, IV hemolysis component
Bilirubinuria causes
hemolytic processes, cholestatis (slowing/block bile flow from liver), secondary to liver disease
What is the confirmatory test for bilirubin?
ictotest (positive is blue/purple color on test mat)
Ketones on dipstick
healthy animals test negative
What causes ketonuria?
shift from carbohydrate metabolism to lipid metabolism, causes negative energy balance and is not sustatinable
What do you most commonly see ketonuria in?
diabetes mellitus, diabetic ketoacidosis, starvation
What is the confirmatory test for ketones?
acetest or ketostix
The lower the pH the more _____ it is.
acidic
The higher the pH the more ____ it is.
alkaline
What is pH heavily influenced by?
diet
The more ____ the urine the more crystal formation and disintegration of RBCs WBCs and casts
alkaline
Normal pH for canine and feline urine
6.0-7.5
Normal pH for horses and cattle urine
7.5-8.5
Protein on dipstick
healthy animals have little to none (kidneys normally filter it out)
What causes proteinuria
renal disease, hemorrhaging, inflammation
What is the confirmatory test for protein in the urine?
suflosalicylic acid precipitation test (SSA) or urine protein: urine creatinine ratio (UPC)
What is the most accurate method for assessing proteinuria?
urine protein: urine creatinine ratio (UPC)
What is a urine protein:urine creatinine ratio used for?
screen for early renal disease, evaluate disease progression or underlying diseases, measure patient response to treatment
How is urine centrifuged?
10 minutes on lower RPM
Where should the microscope condensor be when evaluating urine sediment?
lowered all the way down and then 1 and 1/2 turns up to be in the middle
Should the light of the microscope be bright or dull when looking at urine sediment?
it should be more dull/less bright
What objectives of the microscope will you be using when looking at urine sediment?
10x and 40x
What is urine supernatant?
the liquid portion that sits on top of the sediment or pellet after being centrifuged (plasma or serum of the urine world)
What is urine supernatent used for?
re-suspend the sediment and run the UPC
What things will you see on low power (10x)?
casts, crystals, fungi, sperm, parasites
What things will you see on high power (40x)?
bacteria, epithelial cells, WBCs, RBCs, fat droplets
What do RBCs look like on urine sediment?
smaller than WBCS, round, clear to pale yellow in color with a yellow ring on the inside
RBC
What do WBCs look like on urine sediment
1.5 to 2 times larger than RBC, round, colorless and may have granules on the inside
WBC

pyuria
increase of WBC in the urine
What is the most common epithelial cell seen in urine?
squamous
What do transitional epithelial cells look like?
2-4 times the size of WBC, vary is shape from round to oval to polygonal
Where do transitional epithelial cells come from?
renal pelvis, ureter, urinary bladder, and urethra
What do renal epithelial cells look like?
larger than WBCs round with round nucleus
What does an increase of renal epithelial cells suggest?
renal tubule damage
What do squamous epithelial cells look like?
largest cell in urine, irregularly shaped, colorless, central nucleus with large amount of cytoplasm
Where do squamous cells orginate from?
vaginal tract, prepuce, or distal urethra
squamous epithelial cells

What is transitional cell carcinoma?
malignant neoplasia of epithelial cells seen with clumping of epithelial cells
transitional epithelial cells

What does bacteria look like on a urine sediment?
smallest urine element, can be either cocci (round) or rods (elongated), colorless, wiggles
Bacteria in urine

What does fat look like in urine?
small, round and can be clumped, colorless to yellow with black ring on outside, refractile and on a different plane (focuses up and down)
fat in urine

Where are casts formed?
loops of Henle, distal tubules, and collecting ducts
What are casts made of?
protein
What are the three types of casts?
hyaline, granular, waxy
What do hyaline casts look like?
vary is size, cylindrical shape with parallel sides, rounded/tapered/straight ends with the same diameter throughout, pale to colorless
Where are casts most commonly seen?
edges of the coverslip
What are causes of hyaline casts?
fever, strenuous exercise, diuretics, protein losing glomerular diseases
hyaline cast

What do granular casts look like?
vary in size, cylindrical with parallel sides, ends are rounded/tapered/straight with the same diameter throughout, pale to colorless, contains cells
granular cast

What do waxy casts look like?
vary in size, cylindrical with parallel sides, ends are blunt or fractured, pale to colorless
What do waxy casts indicate?
acute or chronic renal injury
Waxy cast

What causes formation of crystals in urine?
pH, temperature, concentration, and solubility of urine
Do refridgerated or fresh urine have more crystals?
refrigerated
What are struvite crystal characteristics?
large, rectangular with a line down the center, look like envelope, coffin, or prism, colorless and refractile